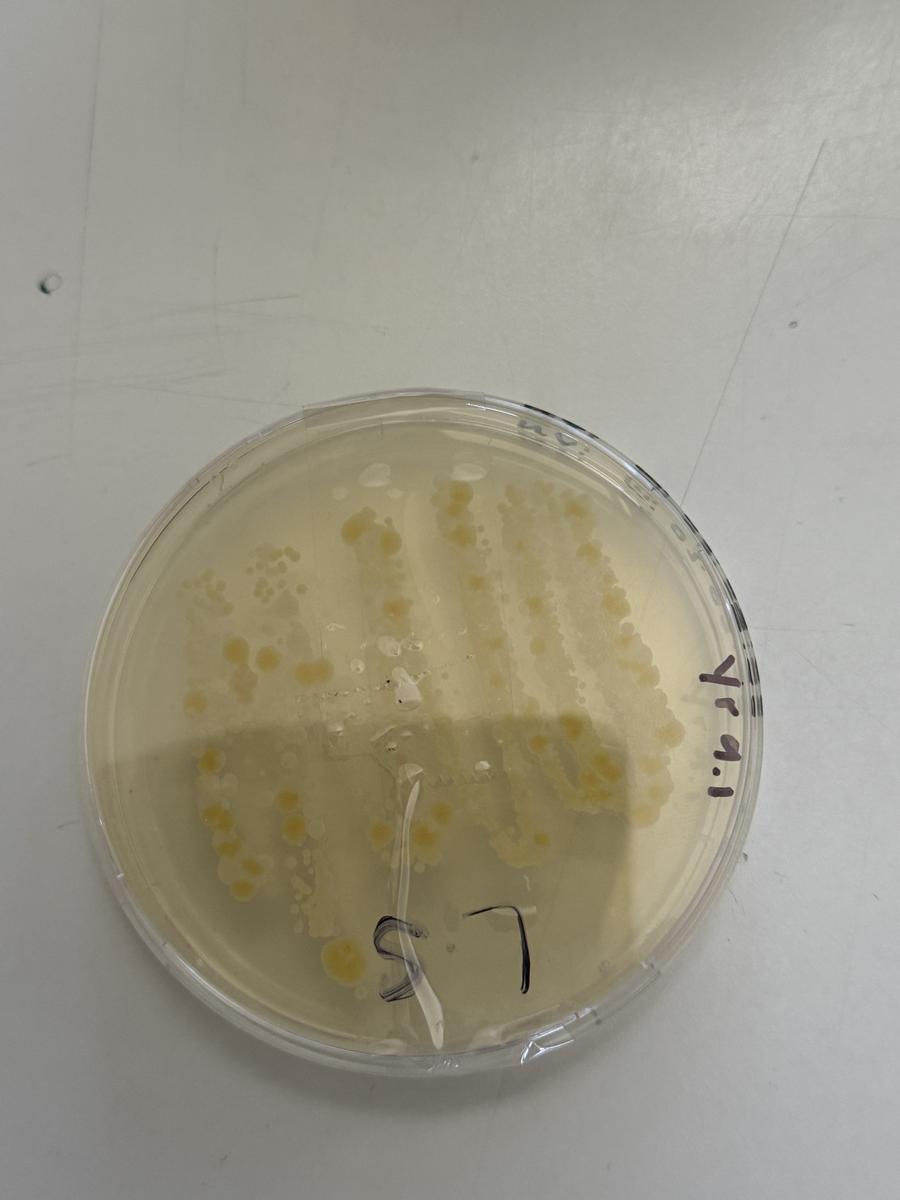

Secondary School

Year 9
Forensic Science in Action
This week, Year 9 Forensic Science students were treated to an exciting and educational visit from Detective Troy Wickham and Crime Scene Investigator Karolyn Formosa. The duo shared their firsthand experiences working in the field of law enforcement and forensic science, offering students a unique glimpse into the world of criminal investigations. Detective Wickham discussed his role in solving complex cases, while Investigator Formosa explained the critical process of gathering and analysing evidence at crime scenes. The highlight of the session was a live demonstration on how to properly lift fingerprints, with students getting hands-on experience using the same techniques that professionals use in real cases.
The visit was an incredible opportunity for students to connect their classroom learning with real-world applications, and they were captivated by the stories and challenges shared by the experts. Detective Wickham and Investigator Harris emphasised the importance of attention to detail, critical thinking, and teamwork in solving crimes. The session not only sparked students’ curiosity about forensic science careers but also inspired them to think about how they can apply scientific methods to uncover the truth. This experience will surely leave a lasting impression on students as they continue their studies in forensic science.
Science: Investigating Bacteria
Year 9 students examined bacteria grown on AGAR plates, using swabs collected from everyday surfaces like car keys, sinks, door handles, and benches. This hands-on experiment provided fascinating insights into microorganisms and hygiene!
2026 Year 7 Open Evening
Are you ready to embark on an exciting journey with your child into secondary education? Join us for our 2026 Year 7 Open Evening on 31 March 2025 from 5:00 pm to 7:00 pm and discover the possibilities that await. This Open Evening session will provide your family with an understanding of our approach to learning and an insight into the value of a Moama Anglican Grammar education for your child.
Why Attend?
- Connect with our passionate, dedicated teachers committed to nurturing your child’s potential.
- Tour our state-of-the-art spaces designed to inspire and engage.
- Discover a wide range of extracurricular and co-curricular opportunities that amplify student’s choices.
- Enjoy engaging sessions led by our staff, offering a genuine glimpse into how we foster your child’s passions, interests, and individual talents.